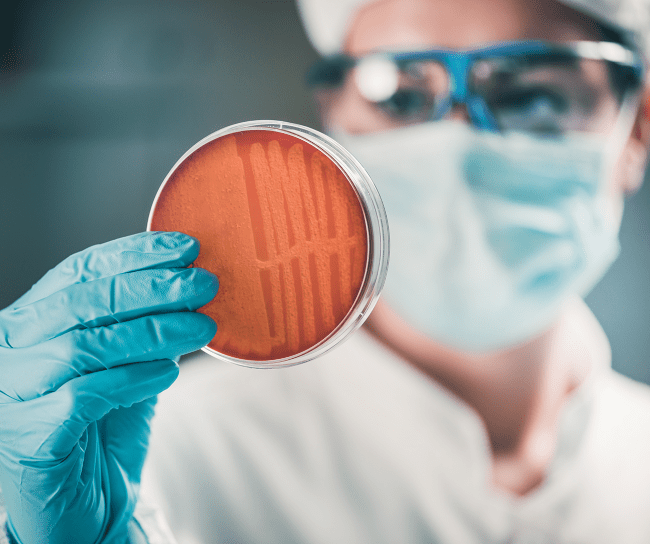

Merck’s legacy of antimicrobial innovation and action
Delivering on our commitment to fight infectious diseases for more than a century
October 12, 2023

For more than 100 years, Merck has contributed to the discovery and development of novel medicines and vaccines to fight infectious diseases. With the growing burden of antimicrobial resistance (AMR), we’ve focused on stopping the increasing threat of AMR.

1930s
Merck Research Laboratories played a central role in the development of sulfas, the first synthetic antimicrobial.

1940s
In collaboration with Rutgers University, we developed streptomycin, the first antibiotic effective against tuberculosis. We also helped to develop one of the first methods for mass production of penicillin.

1950s & 1960s
We developed multiple novel methods to prevent infectious diseases, including pediatric vaccines.

1970s & 1980s
We received U.S. Food and Drug Administration (FDA) approval for two vaccines, as well as three antibiotics that treat a variety of bacterial infections.

1990s & 2000s
Merck received U.S. FDA approval for two antifungals, as well as licenses for two vaccines.
2002
With resistance to antibiotics developing faster through people, animals and the environment, we launched one of the world’s largest and longest-running antimicrobial resistance surveillance studies. Called the Study for Monitoring Antimicrobial Resistance Trends (SMART), the program enables researchers to monitor and identify trends in the development of AMR.

2010s
We launched an Antimicrobial Stewardship (AMS) Investigator Initiated Studies program, supporting investigator-based, peer-reviewed research supporting the implementation of AMS principles across the globe, with over 20% of studies occurring in low-and middle-income countries.

2016
We created the Merck Exploratory Science Center in Cambridge, Massachusetts, focusing on the earliest stages of research into the underlying biology of human disease.

2016-2017
We supported the first United Nations high-level meeting on AMR and subsequent political declaration in 2016, which set policy action on AMR in motion.
As a next step, we joined the newly founded AMR Industry Alliance – a network of over 100 pharmaceutical industry partners working to provide sustainable solutions to help curb antimicrobial resistance.

2020
Merck, along with a group of more than 20 leading biopharmaceutical companies, launched the AMR Action Fund to bring 2-4 new antibiotics to patients by the end of the decade.

2020s
Our staff have championed government actions to create supportive markets for antimicrobial innovation, including the PASTEUR Act in the U.S., inclusion of transferable exclusivity extensions in the EU pharmaceutical strategy, and other incentives around the world.
By collaborating with policymakers, Merck aims to improve appropriate antibiotic use globally.

Going forward
In recognition of our leadership in both human and animal health, Merck represents industry in the One Health Global Leaders Group on Antimicrobial Resistance, which advocates for a One Health approach to help ensure antibiotics remain an important tool in improving and maintaining human and animal health.